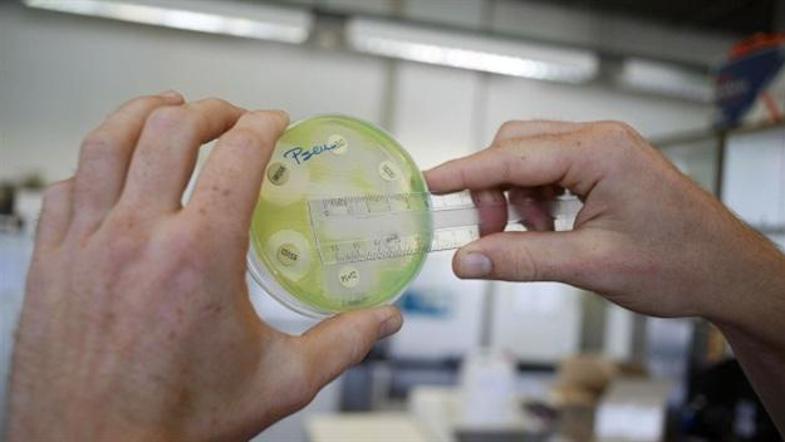
V britanskih bolnišnicah imajo vse več primerov sicer vsakdanjih bakterij, ki so

Belgijski mediji poročajo, da je moški junija letos v Pakistanu utrpel hudo prometno nesrečo, namestili so ga v eno izmed pakistanskih bolnišnic, kjer so mu oskrbeli odprto rano na nogi, nakar se je vrnil v Belgijo. V času, ko se je oglasil pri osebnem zdravniku, je bil že okužen z bakterijo, ki vsebuje encim NDM-1, kar pomeni, da je odporna tudi na najmočnejše do zdaj znane antibiotike carbaneme. Ti se uporabljajo zgolj za nujne primere in za zdravljenje res trdovratnih okužb z drugimi odpornimi bakterijami.
Moškega so poskušali rešiti z vsemi možnimi terapijami, vendar je v nekaj dneh umrl zaradi zastrupitve krvi, tako imenovane sepse. Mikrobiolog Denis Pierard, ki je zdravil umrlega bolnika, je medijem povedal, da je bil moški sicer že drugi primer okužbe z bakterijo NDM-1 letos.
Izogibanje posegom v Indiji in Pakistanu
Bakterije s tem encimom so sicer najpogostejše v Indiji in Pakistanu, v Evropo pa so se razširile predvsem z ljudmi, ki so se v Indijo in Pakistan odpravili na lepotne operacije ali presaditve organov. Britanski mediji so pred nekaj dnevi poročali o okužbah 37 Britancev, ki so bili v zadnji mesecih zdravljeni ali operirani v kateri od bolnišnic južne Azije.
IVZ svetuje previdnost pri odločanju za zdravstvene posege v Pakistanu in Indiji, za turiste, ki se namenjajo v omenjeni državi, pa ne vidijo večje nevarnosti, vsekakor pa svetujejo ustrezno skrb za higieno in previdnost pri uživanju surove hrane.
Prva žrtev odporne bakterije
Moški iz Belgije, ki je danes umrl v bruseljski bolnišnici, je prva žrtev bakterije, ki je zaradi prisotnosti encima New Delhi metallo-β-lactamase 1 (NDM-1) odporna tudi na najmočnejše antibiotike.
Po doslej znanih podatkih sicer v Sloveniji primera NDM-1 še ni bilo, čeprav so slovenski imunologi pri bolnikih, ki so se zdravili v kateri od azijskih držav, že pred leti zasledili prisotnost za antibiotike odpornejših bakterij.




